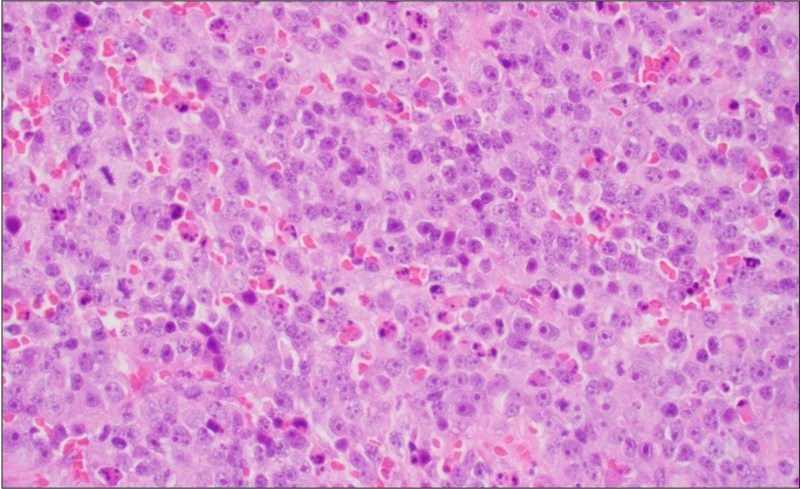

Page 1
Go to: SRBCT page, Neuroblastoma page
Go to: Clinical Presentation, Light Microscopy, IHC
Clinical Presentation
A previously healthy 3-year-old female presented with intermittent sharp abdominal pain.
Radiology:

- CT chest: a retroperitoneal mass, measuring 12.9 x 11.1 x 8.2 cm, arising in the right adrenal gland and extending into the hilum of the right kidney.
- MIBG scan showed MIBG accumulation at the site of the intra-abdominal mass.
Go to: Clinical Presentation, Light Microscopy, IHC
Light Microscopic Findings
Immunohistochemical Staining
Go to: Clinical Presentation, Light Microscopy,IHC
IHC panel for SRBCTs

Immunohistochemical Staining


- Negative: myogenin, desmin, WT1, NKX2.2, CD99

